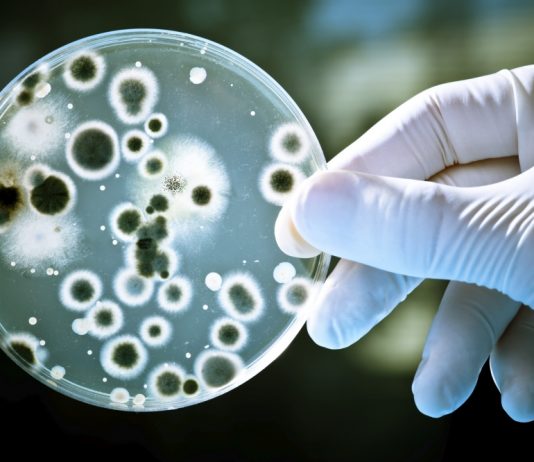
Top 13 most dangerous diseases in the world Top 5 most dangerous diseases in the world

The pure form of anything is always the best and beneficial for health. Brown rice is one of the most beneficial grains that you...
Checkout the realtime Coronavirus stats on Topcount. With Coronavirus map and historical data, the covid-19 tracker also gives you information in detail about deaths, positive cases and recovered patients in different countries like USA, India, China, UK, Italy, Spain, France etc...
If you are reading this than you are surely thinking to quit smoking or you have already put some efforts for the same or...
Nations think about pollution and global warming only once in the year. They meet, they discuss, they curse each other, they frame other countries...
With the help of TV advertisements on food products, the term micronutrients are now quite familiar to all of us. But what the micronutrients...
We have designed a special GM Diet plan for al 7 days. You can follow this plan to lose weight in 7 days, or you can find alternatives based on this plan.
We groove to the tunes of our favourite stars, where some of us want to dance just like them or at least try to. Many...
With gyms multiplying in number in Hyderabad, some Gyms turn out to be a complete workout methodologygy from Weights to cardio as well as Crossfit. Discussing these points into consideration we have the Top 10 Gyms in Hyderabad.
To gain your energy and also, quench your thirst is an energy drink, here is a list of best energy drinks in India. 5. blue energy drink, 4. cuba energy drink
Brown rice is recognized as a nutrient-rich food because it is unpolished. Checkout.. list of highly unpolished and recognized brown rice brand which must be included in the regular diet for staying fit..
Human Immunodeficiency Virus (HIV) possibly one of those diseases which might top in the list of those diseases for which Man doesn't have a...
"God can't be everywhere to give us happiness that's why he gave us Wine" , said by one of the anonymous person. Wine has...
The secret for any pharmaceutical company is having an online medicine app. It not only benefits them but also benefits the customers who are...
Food lovers all around the world love different varieties of food and there are special places where they can avail them. Mumbai is the...
What is Hema Malini not telling you? Is there something regarding your daily routine and health she should tell you. Surprisingly Yes!
It is...
You will be surprised to know a number of pros that avocado has to offer for your health. Read more...
Being fat or a little too overweight becomes a hell of a task! And the torture is usually not from the weight that you...
Hyderabad’s 10 Most Advanced Multi-Speciality Hospitals. These hospitals are important sources of Foreign Medical tourism and Foreign Exchange in India as they are able to cater to the needs of people having complicated problems at the most affordable rates possible.
Right now World is facing one of the disastrous pandemics. Coronavirus has shaken the whole world and is not in a mood to leave...
Indian States - Coronavirus Stats Coronavirus Live Updates (India) The global total number of Corona Virus (COVID-19) confirmed cases reported are . It is unfortunate that,...






































![Best 5 Brown Rice Brands in India [Unpolished]](https://www.topcount.co/wp-content/uploads/2016/02/Highly-Unpolished-Brand-of-Brown-Rice-topcount-534x462.jpg)